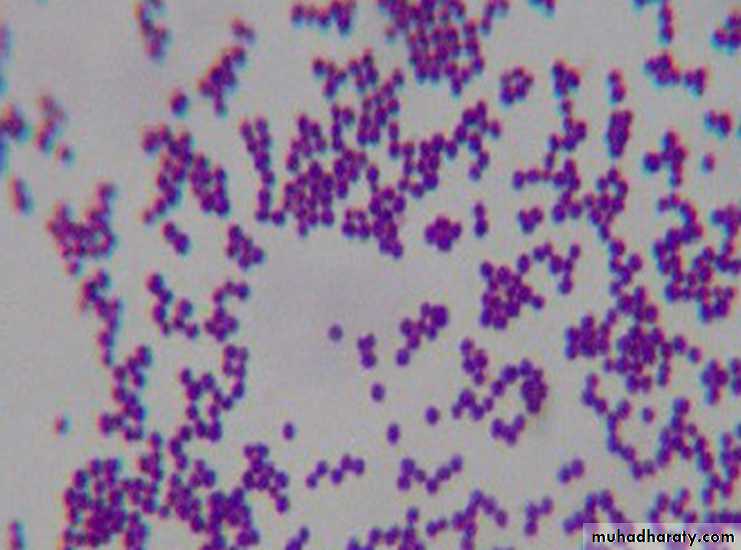
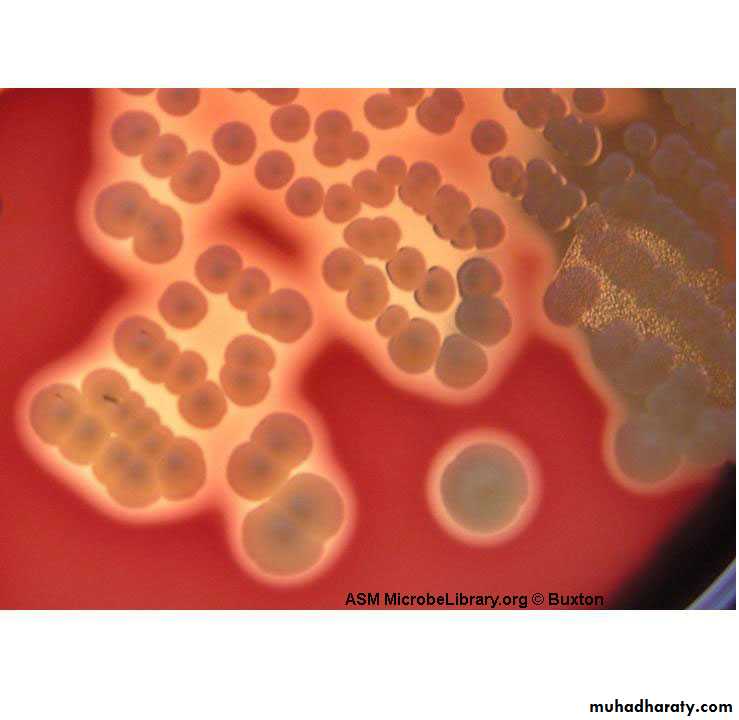
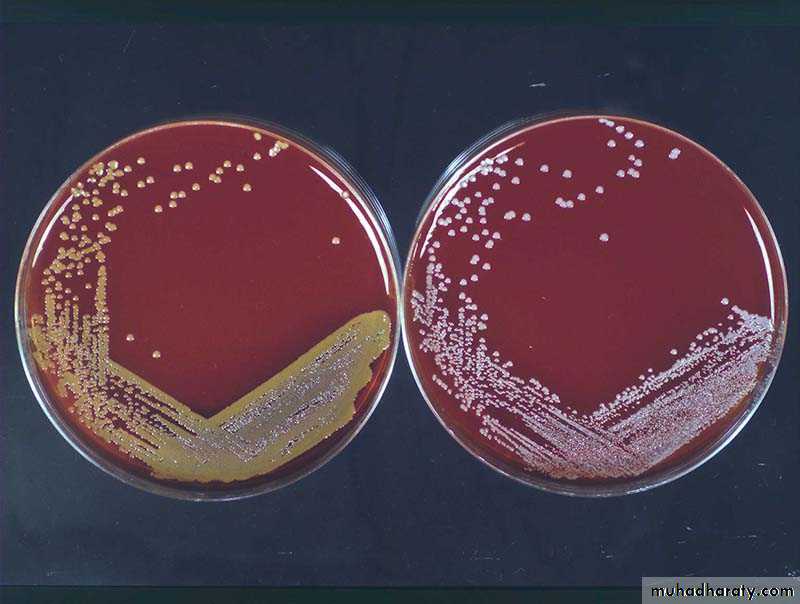
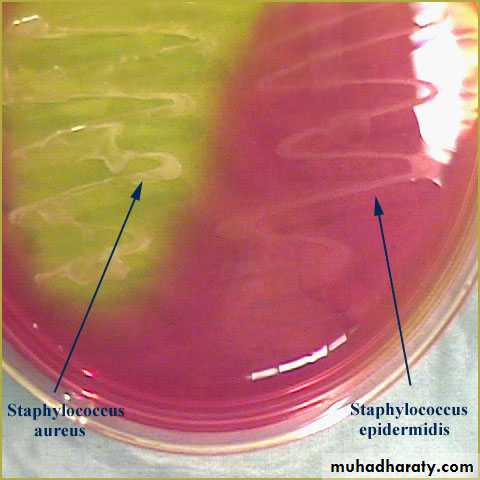
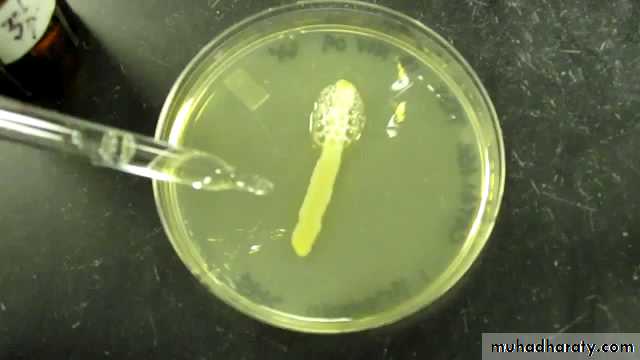
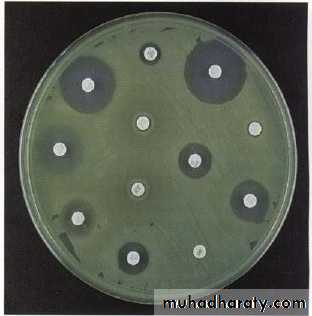
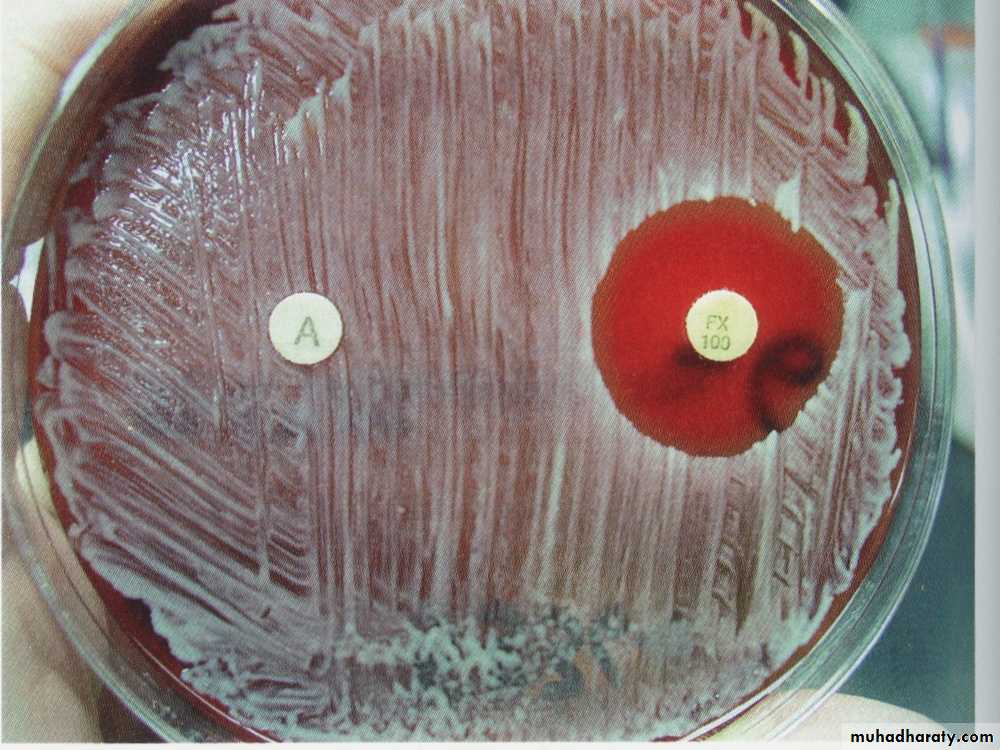

Genus Staphylococci
Gram’s positive, Catalase positive cocci• Lec. 1
• Department of Microbiology
• College of Medicine
• University of Baghdad
• 2013-2014
• Dr. Sarmad M.H Zeiny
OBJECTIVES: Upon completion of this lecture, the student will:
Outline the medically important staphylococci species.Describing the morphology & physiology for staphylococci.
Determine the virulence factors for staphylococci.
Analyze the diseases & pathogenicity for staphylococci.
Demonstrate the epidemiology/transmission for staphylococci.
Outline the laboratory diagnosis for staphylococci.
State the drug of choice and prophylaxis where regularly used.
Analyze a suspected cases of staphylococci infections.
Genus Staphylococci divided in general into 2 types:
Important Properties of genus staphylococcus:The Shape: Staphylococci are spherical gram-positive cocci
Arrangement: arranged in irregular grapelike clusters (Figure 1).
Biochemically:
- All staphylococci produce catalase enzyme.-S.aureus produces coagulase enzyme called coagulase positive staphylococcus.
• -S.epidermidis and S.saprophyticus are coagulase-negative staphylococci.
Continuation Important Properties….
All Staphylococci tolerate high salt concentration (up to 9.5% Nacl).S.aureus produces a pigment called staphyloxanthin, which imparts a golden color to its colonies.
S. aureus usually ferments mannitol and hemolyze RBC (β-hemolysis), whereas the others do not.
S.saprophyticus resistant to novobiocin (type of antibiotic) while others are sensitive.
Staphylococci are non-motile and do not forms spores.
S.aureus on blood agar: β-hemolysis
S.aureus
S.epidermidis(Staphylococcus albus)
golden
white
MANNITOL SALT AGAR
NaCl 7% selectiveMannitol differential
Staphylococcus aureus (Staphylococcus pyogenes):Distinguishing Features:
Small, yellow colonies on blood agar.
β – hemolytic on blood agar (complete destruction of RBC).
Coagulase positive (all other Staphylococcus species are negative).
Ferments mannitol on mannitol salt agar.
Reservoir:
• Normal flora- Nasal mucosa (25-% of population are carriers)
- Skin
Transmission:
• Hands
• Sneezing
• Surgical wounds
• Contaminated food:
- Custard pastries
- Potato salad
- Canned meats
• Virulent factors and pathogenesis:
• a) Proteins That Disable Our Immune Defenses:
• Protein A: protect the organism from opsonization and phagocytosis.
• Coagulase: This enzyme can lead to fibrin formation.
• Hemolysins: They destroy red blood cells, neutrophils, macrophages, and platelets.
• Leukocidins: They destroy leukocytes (white blood cells).
• Penicillinase: This is a secreted form of beta-lactamase.
• Novel penicillin binding protein (transpeptidase): Some strains of Staphylococcus aureus have new penicillin binding proteins that are resistant to penicillinase - resistant penicillins and cephalosporins.
• Staphylococcus aureus wielding protein A and coagulase shields, defending itself from attacking antibodies and phagocytosis.
•
•
• Luckless red blood cell following a neutrophil, running to destruction at the hands of Staphylococcus aureus and its hemolysin and leukocidin dynamite.
•
• b) Proteins to Tunnel Through Tissue:
• Hyaluronidase ("Spreading Factor"): This protein breaks down proteoglycans in connective tissue.• Staphylokinase: This protein lyses formed fibrin clots (like streptokinase).
• Lipase: This enzyme degrades fats and oils, facilitates S. aureus colonization of sebaceous glands.
• Protease: destroys tissue proteins.
• Staphylococcus aureus produces proteins that allow the bacteria to tunnel through tissue.
•
• Staphylococcus aureus produces exotoxin assault weaponry.
• c) Exotoxin:• Exfoliatin: A diffusible exotoxin that causes the skin to slough off ( SSS “scalded skin syndrome”).
• Enterotoxins (heat stable): Exotoxins which cause food poisoning. See fig.
• Toxic Shock Syndrome toxin (TSST-1):
• Causes toxic shock syndrome.
• Found in 20% of S. aureus isolates.
• Superantigens which bind to the MHC class II.
• Causes a massive T cell response and outpouring of cytokines, resulting in the toxic shock syndrome described below. (See Fig.).
• Staphylococcus aureus gastroenteritis.
• Toxic shock syndrome caused by Staphylococcus aureus releasing TSST-1.• Diseases:
Disease caused by exotoxin release:• Gastroenteritis (food poisoning).
• Toxic shock syndrome.
• Scalded skin syndrome(SSS).
Disease resulting from direct organ invasion:
• Pneumonia
• Meningitis
• Osteomyelitis (most common cause).
• Acute bacterial endocarditis (rapid and destructive, emergency case)
• Septic arthritis (most common cause in pediatric age and adult above 50, emergency case)
• Skin infections (Folliculitis, Pustule, Boil (furuncle): e.g. Stye, Carbuncle, Impetigo, cellulites).
• Bacteremia/sepsis.
• Urinary tract infection.
• Diseases caused by direct organ invasion by Staphylococcus aureus. Visualize the Staph-wielding wizard. (Note the cluster of staphylococci at the head of his staff.)
SOFT PAIN
الحصف
Impetigo
Stye
Predisposing Factors for Infection:Surgery/wounds
Foreign body (tampons, surgical packing, sutures)
Severe neutropenia (<500/ µl)
Intravenous drug abuse.
Chronic granulomatous disease
Cystic fibrosis
Staphylococcus aureus and antibiotics:
• 90% of S.aureus produces β-lactamase (penicillinase) degrades penicillins. Rx. With β-lactamase–resistant penicillins, e.g., nafcillin or cloxacillin, plasmid controlled.• Methicillin-resistant S.aureus (MRSA) & Nafcillin-resistant S.aureus (NRSA).
• 50% of S.aureus strains isolated from hospital patients
• Penicillin-binding protein (PBP) changed, chromosome controlled.
• Rx. With vancomycin.
• Resistance to vancomycin, Intermediate (VISA) and full (VRSA).
• Plasmid controlled.
• Note: MRSA, NRSA, VRSA & VISA can be treated with either Linezolid, quinupristin/dalfopristin or daptomycin.
So S.aureus can resist antibiotics by:
• β –lactamase production, encoded by plasmid.
• Change in molecular structure of PBP, encoded by bacterial chromosome.
• Resistant to Vancomycin, transmitted from other bacteria, encoded by plasmid.
• Staphylococcus epidermidis (Staphylococcus albus):
• Normal bacterial flora of the human skin.• It is coagulase-negative.
• Infections are almost always hospital-acquired:
• Diseases: Infections of prosthetic devices in the body,
• -Most frequent organism,
• - Polysaccharide capsule (slime layer) that allows adherence.
• Highly antibiotic resistant. β-lactamase, The drug of choice is vancomycin.
• Staphylococcus saprophyticus
• This organism is a leading cause (second only to E.coli) of urinary tract infections (UTI) in sexually active young women "Honeymoon cystitis".• It is most commonly acquired by females in the community (NOT in the hospital).
• This organism is coagulase-negative.
• Resistant to novobiocin.
DR.SARMAD ZEINY,MBChB,MSc.
16
5
3
4
2
1
2
3
1
2
4
3
1
2
6
5
4
3
1
2
6
5
4
3
1
2
1) Specimens:
Pus, exudates.
Swabs.
Urine.
C.S.F.
Sputum.
Blood In Cases Of Septicemia.
Gram’s positive cocci, Grape-like arrangment (clusters)
2) Gram’s slide:• Blood agar: see large, round, smooth, raised & glistening white or golden color, B-hemolysis if S.aureus.
• Mannitol Salt Agar:
- S.aurues: yellowish discoloration of media
- Other Staphylococcui: no discoloration (remains pink media)
3) Culture:
S.aureus on blood agar: β-hemolysis
s.aureus
s.epidermidisMANNITOL SALT AGAR
NaCl 7% selectiveMannitol differential
4) Biochemical tests:Coagulase test:
(+ve only in S.aureus )
Catalase test:
H2O2H2O & O2
DETECT the ability of S. aureus to clot blood plasma (fibrinogen fibrin).
Tube method
Slide method
To differentiate between Staph. & Strepto.
Coagulase test
+ve
-ve
-ve
+ve
Catalase test
5) Serological test : slide method, Latex agglutination test to detect S.aureus.
6) Antibiotic Sensitivity test:Used to
• Detect MRSA &VRSA
• Very important because S.aureus is resistant to B-lactam drugs i.e. penicillins.
Antibiotics disc
Zone of inhibition (no growth)Antibiotic Sensitivity test by disc diffusion method
Zone of inhibition
Antibiotic Sensitivity test
Prevention:• There is no vaccine against staphylococci.
• Cleanliness, frequent hand washing, and aseptic management of lesions help to control spread of Sta. aureus.
• Intranasal mupirocin or by oral antibiotics, such as ciprofloxacin or trimethoprim-sulfamethoxazole, but is difficult to eliminate completely.
• Shedders may have to be removed from high-risk areas, e.g., operating rooms and newborn nurseries.
• Cefazolin is often used perioperatively to prevent staphylococcal surgical-wound infections.
Summary:
S.aureus is the most pathogenic species because of their virulent factors.S.aureus colonizes nasal mucosa (25% of population are carriers)
Staphylococci easily diagnosed in the lab. By using Gram’s staining, culture and biochemical tests.
S.aureus and S.epidermidis are highly antibiotic resistance and causing nasty hospital acquired infections.
Staphylococci infection can be prevented by regular hygiene precautions and by antibiotics, no vaccine.